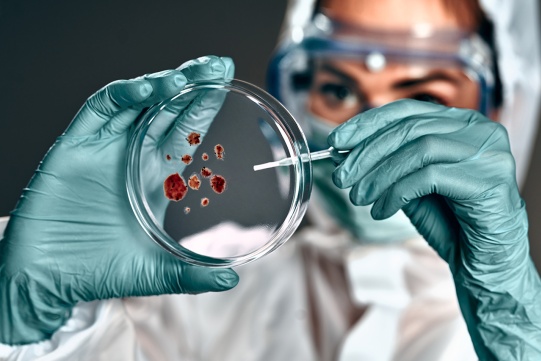
Naukowczyni w laboratorium

I Konferencja Zespołów koordynujących program "Inicjatywa Doskonałości - Uczelnia Badawcza"
Celem konferencji było nawiązanie wzajemnych kontaktów z członkami zespołów realizujących program IDUB, wymiana doświadczeń dotyczących wdrażania oraz realizacji programu, wypracowanie ogólnouczelnianych rozwiązań oraz networking.